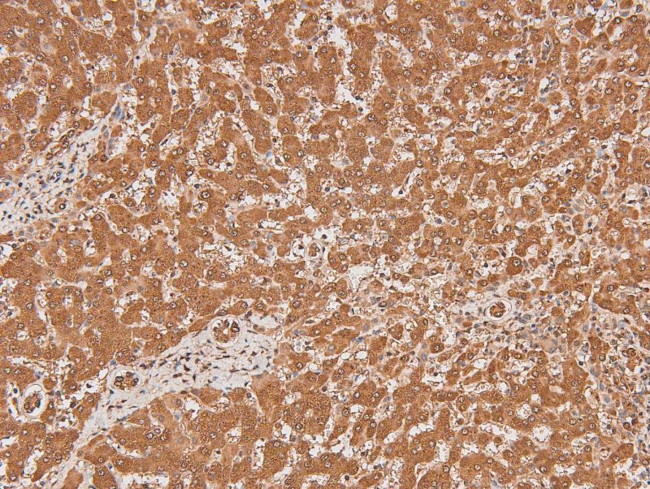
Phospho-FLT3 (Tyr591) Antibody in Immunohistochemistry (Paraffin) (IHC (P))

Search
Invitrogen
Phospho-FLT3 (Tyr591) Polyclonal Antibody
{{$productOrderCtrl.translations['antibody.pdp.commerceCard.promotion.promotions']}}
{{$productOrderCtrl.translations['antibody.pdp.commerceCard.promotion.viewpromo']}}
{{$productOrderCtrl.translations['antibody.pdp.commerceCard.promotion.promocode']}}: {{promo.promoCode}} {{promo.promoTitle}} {{promo.promoDescription}}. {{$productOrderCtrl.translations['antibody.pdp.commerceCard.promotion.learnmore']}}
图: 1 / 5
Phospho-FLT3 (Tyr591) Antibody (PA5-105884) in IHC (P)





Please note: We are reviewing Western blot images included in the antibody testing data in our catalog, including those provided by third parties. Unless expressly labeled or annotated as “raw-unedited”, Western blot images included in the antibody testing data in our catalog may have been edited, optimized or otherwise adjusted for presentation.
产品信息
PA5-105884
种属反应
宿主/亚型
分类
类型
抗原
偶联物
形式
浓度
规格
纯化类型
保存液
内含物
保存条件
运输条件
RRID
产品详细信息
Antibody detects endogenous levels of Flt3 / CD135 only when phosphorylated at Tyr591.
靶标信息
FLT3 is a tyrosine protein kinase that is a member of the growth factor receptor tyrosine kinase family. The receptor is activated by binding of the fms-related tyrosine kinase 3 ligand to the extracellular domain, which induces homodimer formation in the plasma membrane leading to autophosphorylation of the receptor. The activated receptor kinase subsequently phosphorylates and activates multiple cytoplasmic effector molecules in pathways involved in apoptosis, proliferation, and differentiation of hematopoietic cells in bone marrow. Mutations that result in the constitutive activation of this receptor result in acute myeloid leukemia and acute lymphoblastic leukemia.
仅用于科研。不用于诊断过程。未经明确授权不得转售。
篇参考文献 (0)
生物信息学
蛋白别名: CD135; Fetal liver kinase 2; Fetal liver kinase-2; FL cytokine receptor; FLK-2; FLT-3; Fms-like tyrosine kinase 3; OTTHUMP00000214829; Receptor-type tyrosine-protein kinase FLT3; RP11-153M24.3; Stem cell tyrosine kinase 1; STK-1; tyrosine-protein kinase FLT3; Tyrosine-protein kinase receptor flk-2
基因别名: B230315G04; CD135; Flk-2; FLK2; Flt-3; FLT3; Ly72; STK1; wmfl
UniProt ID: (Mouse) Q00342
Entrez Gene ID: (Rat) 140635, (Mouse) 14255